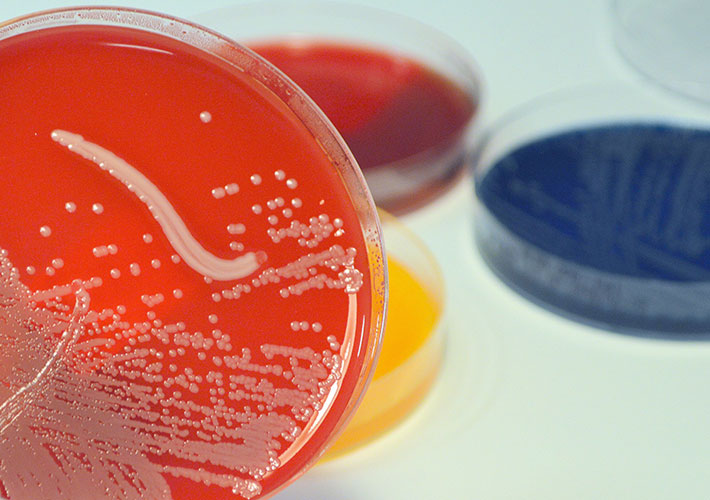
News image

Oct 22, 2018
A new ASTM International standard will help determine the effectiveness of antimicrobials and disinfectants against biofilms. This new test method, soon to be published as E3180, was developed by ASTM’s committee on pesticides, antimicrobials, and alternative control agents (E35).
Bacterial spores, and biofilms, slimy films of bacteria that adhere to surfaces, are highly resistant to antimicrobials. When spores are embedded in the biofilm extracellular substance, the effectiveness of disinfectants can be reduced.
According to ASTM International member Laura Wahlen, research scientist, Baxter Healthcare Corporation, this new test method will serve as a protocol to produce and quantify a reproducible biofilm containing spores that can be used to analyze the effect of various treatment such as antibiotics, disinfectants, or heat.
Wahlen says that members of the drug, medical device, and antimicrobial industries will find this standard most useful. “They can use this standard to analyze the efficacy of antimicrobials or disinfection processes against a potentially resistant biofilm with spores.”
The committee is currently seeking participants for an Interlaboratory Study Program that will take place in the next year.
ASTM welcomes participation in the development of its standards. Become a member at www.astm.org/JOIN.
To purchase standards, contact ASTM International customer relations (tel +1.877.909.ASTM; sales@astm.org).
January / February 2019